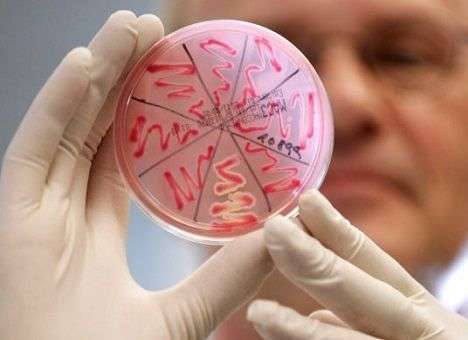
Эксперты предупредили о надвигающейся эпидемии

Рубрики
МЕНЮ
Эксперты предупредили о надвигающейся эпидемии
Мутированный вирус научился обходить иммунитет

Виталий Войчук
Австралийские эксперты предупреждают: в ближайшие 2-7 месяцев мир может накрыть эпидемия гастроэнтерита, передает "meddaily.ru".
Ученые обнаружили опасный штамм норовируса, вызывающего это заболевание. Впервые штамм выявили в августе 2015 года. И за это время он значительно мутировал, научившись обходить иммунитет. У вируса есть все, чтобы стать пандемическим штаммом.
Отталкиваясь от статистики за 14 лет, ученые спрогнозировали: в ближайшее время штамм, вероятно, начнет угрожать не только Австралии, но и всему миру. Они подчеркивают, что данный штамм генетически отличается от всех остальных, и это делает его особо опасным.
К тому же, человеческий организм просто не успевает подстроиться к новым мутациям, что делает его беззащитным. Значит, в теории любой человек рискует заразиться, хотя наибольшую угрозу вирус представляет для детей младше пяти лет и пожилых людей. Инфицирование может произойти при контакте с фекалиями зараженного человека или с рвотой.
Фото: golden-news.com
Читайте Comments.ua в Google News
Новости партнеров



